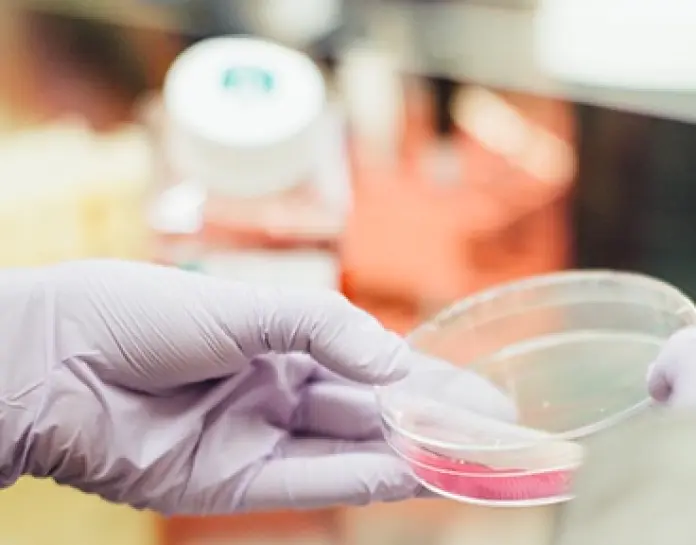
New Model for Device Trials: Public Consultation

Don’t miss our content
SubscribeA significant step for clinical research in Portugal
Clinical research on medical devices in Portugal is governed by a well-established regulatory framework, rooted in Regulation (EU) 2017/745, of 5 April 2017 and Law No. 21/2014, of 16 April. Within this framework, a Financial Agreement is, in certain cases, a legal requirement for the conduct of clinical trials.
Recognising the importance of harmonisation and efficiency, the Ethics Committee for Clinical Research (CEIC) has prepared a draft model financial agreement specifically for clinical research involving medical devices. The purpose is clear: to facilitate the initiation and conduct of such studies and reinforce Portugal’s attractiveness as a host country for clinical trials in the field of medical technologies.
A collaborative draft under public consultation
The draft model has been developed by a multidisciplinary working group, including representatives of key stakeholders in the sector. This collaborative approach is intended to ensure that the final version:
- reflects international best practices;
- safeguards the interests of all parties involved (sponsors, CROs, investigators, and healthcare institutions);
- provides contractual clarity, transparency, and legal certainty.
Given the potential impact, CEIC highlights the importance of broad participation in the consultation process, so that the final model benefits from the perspectives of all relevant actors.
Why this consultation matters
This is a unique opportunity for medical device companies, hospitals, CROs, and investigators to contribute to shaping the contractual framework that will likely underpin most device trials in Portugal going forward.
By engaging in this process, stakeholders can help to:
- promote balanced agreements that reflect the realities of clinical practice;
- reduce administrative hurdles;
- ensure Portugal remains competitive in attracting high-quality clinical research.
Next steps
CEIC invites all interested parties to submit their comments and suggestions by 15 October 2025, through the link provided on its official website.
The new financial agreement model may become a reference point for future clinical research on medical devices in Portugal. Stakeholder contributions will, therefore, be important to ensure that the final version combines legal robustness, contractual balance, and operational efficiency.
Don’t miss our content
Subscribe